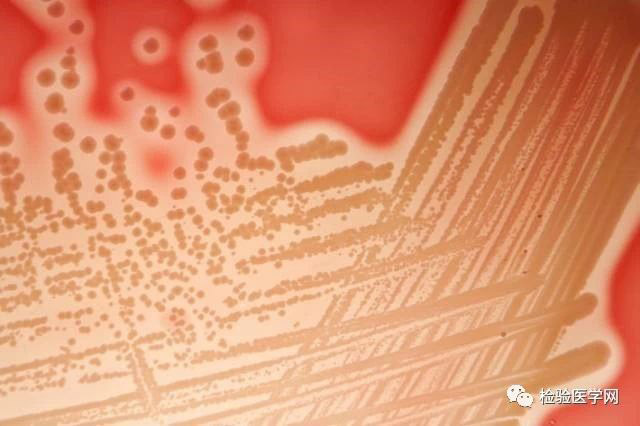

作者:天津医科大学肿瘤医院检验科 李丁
干燥的春季是老人儿童呼吸道感染的高发季节,各种病毒细菌极易侵入上呼吸道,造成感染,提到上呼吸道感染,大家第一反应就是流感,事实上,流感病毒所造成感染在整个上呼吸道感染中所占的比例有限,根据中国流感监测网络2019年第1周的监测数据,我国内地南北方省份流感已经进入流行高峰期,但北方哨点医院报告的流感样病例占就诊病例总数的百分比也仅为5.3%。我们今天想给大家介绍的是另一种易造成上感、引起患者高热、咽痛的病原菌——金黄色葡萄球菌。 金黄色葡萄球菌是一种革兰阳性菌,镜下呈葡萄状排列,培养过程中会产生完全溶血环,金黄色葡萄球菌造成的感染主要是院内获得性肺炎和皮肤软组织感染,如毛囊炎、疖、痈等,如果侵入深部也可以造成肺炎、关节炎、中耳炎等,任何部位的金黄色葡萄球菌感染都能够入血造成菌血症。 那么它是怎么造成上呼吸道感染的呢,扁桃体作为人体的免疫器官之一,负责抵御外来病原菌入侵,金黄色葡萄球菌也是其抵御的敌人之一,一旦抵御失败,扁桃体就会发生化脓性感染,患者表现为咽喉剧烈疼痛,畏寒,高热可达39~40℃,但是缺乏一般上呼吸道感染常见的打喷嚏,流涕等。观察扁桃体可见红肿,以及黄白相间的化脓性改变,使用咽拭子取病变部位分泌物进行培养,可以分离到金黄色葡萄球菌。 在治疗方面,需要使用抗生素,一般社区感染的金黄色葡萄球菌多为苯唑西林敏感株,可以使用头孢菌素类药物治疗,如果患者对青霉素类药物过敏,可以选择克林霉素;而医院获得性感染的菌株耐苯唑西林比例较高,应根据药敏结果进行用药。 所以,当出现高热、咽痛还是应该到医院就诊,找出病因,对症下药才是上策。 【参考文献】 [1]张秀珍,朱德妹.临床微生物检验问与答.人民卫生出版社,2008年,第1版.